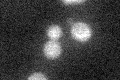
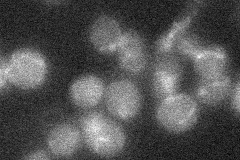

View description
Probable membrane protein with three predicted transmembrane domains; homologous to Ybr042cp, similar to C. elegans F55A11.5 and maize 1-acyl-glycerol-3-phosphate acyltransferase
Localization:
Intensity:
Fold change:
Significance:
-
C’ GFP library in SD
below threshold17.34 -
N' NOP1pr-GFP in SD

ER44.4158 -
N' TEF2pr-mCherry in SD

ER,vacuole56.0971 -
N' NATIVEpr-GFP in SD
below threshold15.9254 -
N' TEF2pr-VC and Cyto-VN in SD

below threshold25.6364 -
C’ GFP library in SD+DTT

cytosol14.470.83No -
C’ GFP library in SD+H2O2

cytosol17.110.98No -
C’ GFP library in Starvation Media

cytosol22.231.28No -
C’ GFP library on the background of Pup2-DaMP

N/A -
C’ GFP library on the background of CCT mutant

N/A0N/AYes
